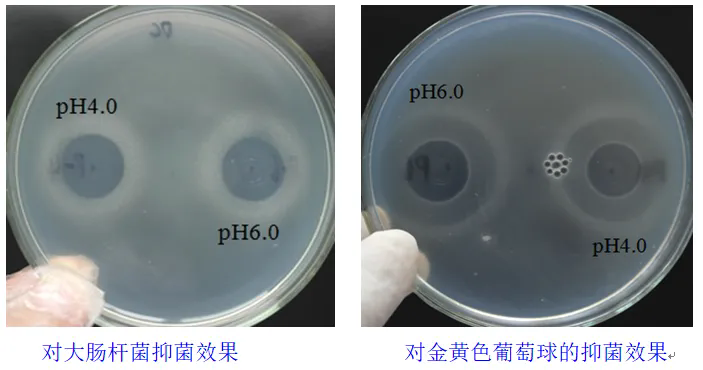
uploads/image/20240628/1719568998.png

抑梭菌、保健康、促生长
【致死性肠炎和产气荚膜梭菌】
随着抗生素在全球范围的禁用,加上现代畜牧业的过度集约化养殖,导致坏死性肠炎的发病率明显上升。而坏死性肠炎的产生主要是由于饲料中含有高蛋白以及高比例的非淀粉多糖,吸收水分导致食糜粘度增加,使得饲料养分分解吸收变差,从而导致产气荚膜梭菌的大量滋生继发引起的。产气荚膜梭菌根据携带的毒素基因种类分为A-E等不同类型,对畜禽都有一定的感染性。在坏死性肠炎中,禽坏死性肠炎在全球范围内最为严重。产气荚膜梭菌及坏死性肠炎的发生,导致畜禽肠道菌群平衡被打破,继而引起肠道黏膜损伤,降低畜禽机体对于养分的吸收利用效率,严重可引起畜禽死亡,导致畜禽生产性能下降,降低经济效益。
【使命】
肠康J-20适用于以产气荚膜梭菌为主的厌氧性细菌引起的肠道炎症,通过免疫增强、抑菌抗感染、平衡肠道菌群和肠道修复四大核心技术打造,抑制畜禽肠道产气荚膜梭菌等厌氧性细菌,维护畜禽肠道菌群平衡,保护畜禽肠道健康。
【特点】—四大核心技术维护畜禽肠道健康
免疫提升:肠康J-20可直接作用于免疫细胞,提高机体免疫球蛋白的含量,促进动物机体免疫器官发育,改善机体免疫系统功能状态,提高特异性和非特异性免疫力,增强机体的抗炎抑菌能力。
抑菌抗感染:肠康J-20具有良好抑制产气荚膜梭菌的功能,能够强有效的从源头解决畜禽致死性肠炎,是最有效非抗生素控制产气荚膜梭菌的方案。
平衡肠道菌群:肠康J-20同样能够促进双歧杆菌、乳酸菌等有益菌的生长,同时还能抑制大肠杆菌、沙门氏菌等有害菌的繁殖,加强畜禽肠道对营养物质的利用效率。
肠道修复:肠康J-20能够有效修复肠道黏膜损伤,维护畜禽肠道健康,提高畜禽肠道对养分的吸收利用率。
不同有益菌抑制产期荚膜梭菌性能

【产品原理】
免疫增强高效抗炎:肠康J-20可直接增强动物机体T、B淋巴细胞的免疫功能,提高免疫球蛋白的含量,增强畜禽机体抗炎能力。
抑制产气荚膜梭菌:肠康J-20在胃肠道前段及后段均能生长;对引发致死性肠炎的产气荚膜梭菌有特效。
抑制病原菌维持菌群平衡:肠康J-20良好抑制能造成动物腹泻的致病性大肠杆菌和沙门氏菌等有害菌,对于肠道有益菌具有促进和益生作用。
修复肠道绒毛与黏膜损伤:消除肠道炎症病灶,修复肠道黏膜损伤,营养肠道绒毛,促进畜禽机体对于营养物质的吸收利用率。

【功效】—阻断肠道炎症、维护肠道稳态、修复炎症损伤、节能增效
【使用方案】
常规用量:每吨配合饲料添加100g;
短期治疗用量:咨询企业技术。